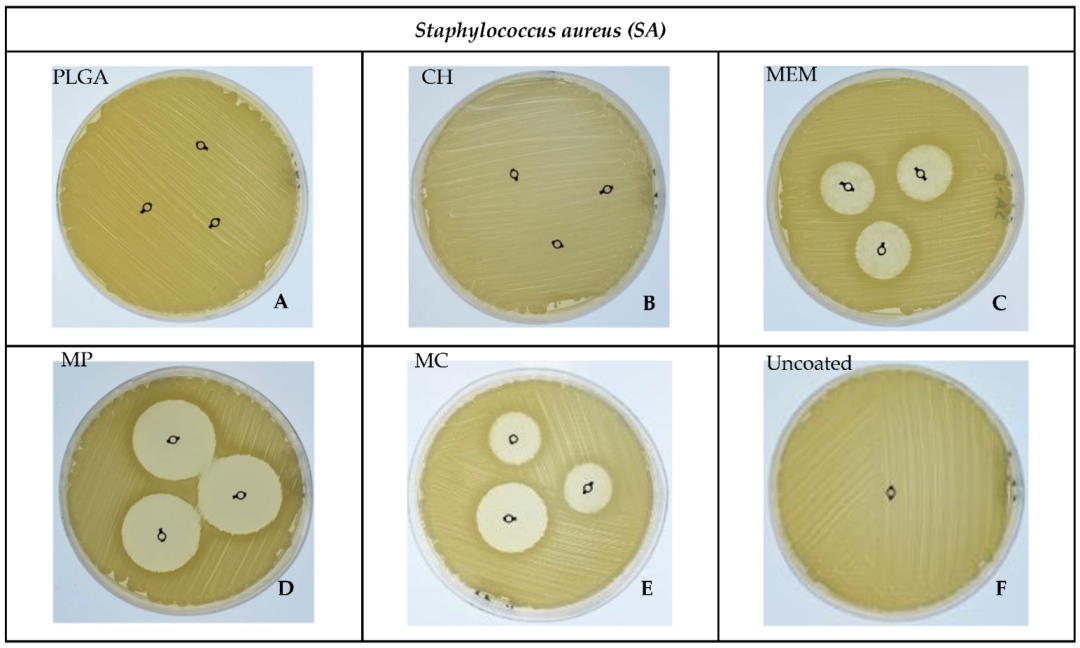
Antibiotics 11 01565 g003
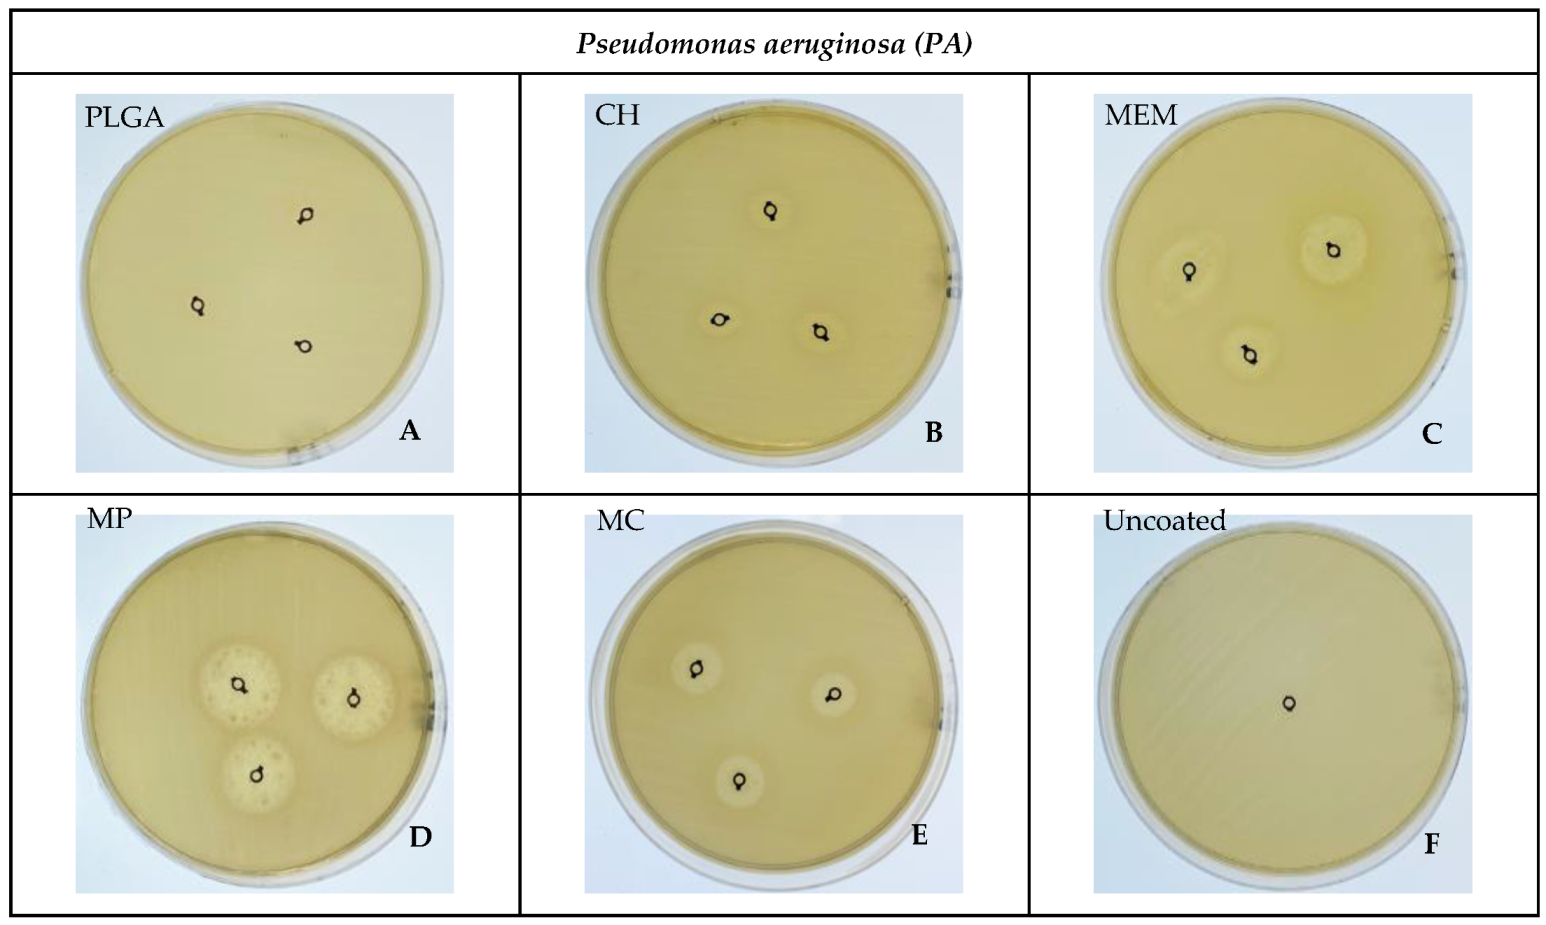
Antibiotics 11 01565 g004

Microbiological Assessment of Titanium Plates Coated with PLGA, Chitosan, and/or Meropenem: An In Vitro Study
Abstract
1. Introduction
2. Materials and Methods
2.1. Samples Preparation
- Solution 1: 25 mg poly lactic-co-glycolic acid “PLGA” and 5 mg meropenem “MEM” in 2.5 mL acetone “MP”.
- Solution 2: 25 mg chitosan “CH” and 5 mg meropenem “MEM” in 2.5 mL acetone “MC”.
- Solution 3: 5 mg meropenem in 2.5 mL acetone “MEM”.
- Solution 4: 25 mg poly lactic-co-glycolic acid in 2.5 mL acetone “PLGA”.
- Solution 5: 25 mg chitosan in 2.5 mL acetone “CH”.
2.2. Bacteria Strains
2.3. Colony-Forming Unit (CFU) Assay
- (A)
- Media Preparation
- (B)
- Bacteria Cultivation
- (C)
- Serial Dilution
- (D)
- Streaking
- (E)
- CFU Counting
2.4. Bacterial Zone of Inhibition (ZOI)
2.5. MTT Assay
2.6. Confocal Microscopy Assessment
2.7. Statistical Analysis
3. Results
3.1. CFUs
3.2. Bacterial ZOI
3.3. MTT
3.4. Confocal Microscope Imaging
4. Discussion
5. Conclusions
Author Contributions
Funding
Institutional Review Board Statement
Informed Consent Statement
Data Availability Statement
Acknowledgments
Conflicts of Interest
References
- Haerle, F.; Champy, M.; Terry, B.C. Atlas of Craniomaxillofacial Osteosynthesis: Microplates, Miniplates, and Screws, 2nd ed.; Thieme: Stuttgart, Germany, 2009; ISBN 978-3-13-116492-6. [Google Scholar]
- Weinstein, A. Implant Retrieval: Material and Biological Analysis; Forgotten Books: London, UK, 1981; ISBN 0-364-60864-1. [Google Scholar]
- Schmidt, B.L.; Perrott, D.H.; Mahan, D.; Kearns, G. The Removal of Plates and Screws after Le Fort I Osteotomy. J. Oral Maxillofac. Surg. 1998, 56, 184–188. [Google Scholar] [CrossRef]
- Turvey, T.A.; Proffit, W.P.; Phillips, C. Biodegradable Fixation for Craniomaxillofacial Surgery: A 10-Year Experience Involving 761 Operations and 745 Patients. Int. J. Oral Maxillofac. Surg. 2011, 40, 244–249. [Google Scholar] [CrossRef] [PubMed]
- Hwang, J.Y.; Li, Z.; Loh, X.J. Small Molecule Therapeutic-Loaded Liposomes as Therapeutic Carriers: From Development to Clinical Applications. RSC Adv. 2016, 6, 70592–70615. [Google Scholar] [CrossRef]
- Ye, C.; Chi, H. A Review of Recent Progress in Drug and Protein Encapsulation: Approaches, Applications and Challenges. Mater. Sci. Eng. C 2018, 83, 233–246. [Google Scholar] [CrossRef] [PubMed]
- Fan, X.; Jiang, S.; Li, Z.; Loh, X.J. Conjugation of Poly(Ethylene Glycol) to Poly(Lactide)-Based Polyelectrolytes: An Effective Method to Modulate Cytotoxicity in Gene Delivery. Mater. Sci. Eng. C 2017, 73, 275–284. [Google Scholar] [CrossRef]
- Dinarvand, R.; Sepehri, N.; Manoochehri, S.; Rouhani, H.; Atyabi, F. Polylactide-Co-Glycolide Nanoparticles for Controlled Delivery of Anticancer Agents. Int. J. Nanomed. 2011, 6, 877–895. [Google Scholar] [CrossRef]
- Ruocco, N.; Costantini, S.; Guariniello, S.; Costantini, M. Polysaccharides from the Marine Environment with Pharmacological, Cosmeceutical and Nutraceutical Potential. Molecules 2016, 21, 551. [Google Scholar] [CrossRef]
- Zhanel, G.G.; Wiebe, R.; Dilay, L.; Thomson, K.; Rubinstein, E.; Hoban, D.J.; Noreddin, A.M.; Karlowsky, J.A. Comparative Review of the Carbapenems. Drugs 2007, 67, 1027–1052. [Google Scholar] [CrossRef]
- Lowy, F.D. Staphylococcus aureus Infections. New Engl. J. Med. 1998, 339, 520–532. [Google Scholar] [CrossRef]
- Fux, C.A.; Costerton, J.W.; Stewart, P.S.; Stoodley, P. Survival Strategies of Infectious Biofilms. Trends Microbiol. 2005, 13, 34–40. [Google Scholar] [CrossRef]
- Moore, N.M.; Flaws, M.L. Introduction: Pseudomonas aeruginosa. Clin. Lab. Sci. 2011, 24, 41–42. [Google Scholar] [CrossRef]
- Costerton, W.; Veeh, R.; Shirtliff, M.; Pasmore, M.; Post, C.; Ehrlich, G. The Application of Biofilm Science to the Study and Control of Chronic Bacterial Infections. J. Clin. Invest 2003, 112, 1466–1477. [Google Scholar] [CrossRef]
- Garric, X.; Garreau, H.; Vert, M.; Molès, J.-P. Behaviors of Keratinocytes and Fibroblasts on Films of PLA50–PEO–PLA50 Triblock Copolymers with Various PLA Segment Lengths. J. Mater. Sci. Mater. Med. 2008, 19, 1645–1651. [Google Scholar] [CrossRef]
- Grela, E.; Kozłowska, J.; Grabowiecka, A. Current Methodology of MTT Assay in Bacteria—A Review. Acta Histochem. 2018, 120, 303–311. [Google Scholar] [CrossRef]
- Van Tonder, A.; Joubert, A.M.; Cromarty, A.D. Limitations of the 3-(4,5-Dimethylthiazol-2-Yl)-2,5-Diphenyl-2H-Tetrazolium Bromide (MTT) Assay When Compared to Three Commonly Used Cell Enumeration Assays. BMC Res. Notes 2015, 8, 47. [Google Scholar] [CrossRef]
- Guillaume, O.; Garric, X.; Lavigne, J.-P.; Van Den Berghe, H.; Coudane, J. Multilayer, Degradable Coating as a Carrier for the Sustained Release of Antibiotics: Preparation and Antimicrobial Efficacy In Vitro. J. Control. Release 2012, 162, 492–501. [Google Scholar] [CrossRef]
- Guillaume, O.; Lavigne, J.-P.; Lefranc, O.; Nottelet, B.; Coudane, J.; Garric, X. New Antibiotic-Eluting Mesh Used for Soft Tissue Reinforcement. Acta Biomater. 2011, 7, 3390–3397. [Google Scholar] [CrossRef]
- Sanders, E.R. Aseptic Laboratory Techniques: Plating Methods. JoVE 2012, 63, 3064. [Google Scholar] [CrossRef]
- Borowicz, S.; Van Scoyk, M.; Avasarala, S.; Karuppusamy Rathinam, M.K.; Tauler, J.; Bikkavilli, R.K.; Winn, R.A. The Soft Agar Colony Formation Assay. JoVE 2014, 92, 51998. [Google Scholar] [CrossRef]
- An, Y.H.; Friedman, R.J. Laboratory Methods for Studies of Bacterial Adhesion. J. Microbiol. Methods 1997, 30, 141–152. [Google Scholar] [CrossRef]
- Ben-David, A.; Davidson, C.E. Estimation Method for Serial Dilution Experiments. J. Microbiol. Methods 2014, 107, 214–221. [Google Scholar] [CrossRef] [PubMed]
- Bhargav, H.S.; Shastri, S.D.; Poornav, S.P.; Darshan, K.M.; Nayak, M.M. Measurement of the Zone of Inhibition of an Antibiotic. In Proceedings of the 2016 IEEE 6th International Conference on Advanced Computing (IACC), Bhimavaram, India, 27–28 February 2016; IEEE: Bhimavaram, India, 2016; pp. 409–414. [Google Scholar]
- Xu, Z.; Liang, Y.; Lin, S.; Chen, D.; Li, B.; Li, L.; Deng, Y. Crystal Violet and XTT Assays on Staphylococcus aureus Biofilm Quantification. Curr. Microbiol. 2016, 73, 474–482. [Google Scholar] [CrossRef]
- IEEE 6th International Conference on Advanced Computing. Available online: https://ieeexplore.ieee.org/xpl/conhome/7510486/proceeding (accessed on 10 October 2022).
- Ikner, L.; Schmitz, B.; Pepper, I.; Gerba, C. Bacterial Growth Curve Analysis and Its Environmental Applications. 2015. Available online: https://www.researchgate.net/publication/323334888_Bacterial_Growth_Curve_Analysis_and_its_Environmental_Applications (accessed on 10 October 2022).
- Lindsay, D.; von Holy, A. Bacterial Biofilms within the Clinical Setting: What Healthcare Professionals Should Know. J. Hosp. Infect. 2006, 64, 313–325. [Google Scholar] [CrossRef]
- Stewart, P.S.; William Costerton, J. Antibiotic Resistance of Bacteria in Biofilms. Lancet 2001, 358, 135–138. [Google Scholar] [CrossRef]
- Ghahramanzadeh Asl, H.; Alsaran, A. In Vitro Comparison of Commercial and Ultrafine-Grained Titanium Osteosynthesis Miniplates Used on Mandibular Fractures. Dent. Med. Probl. 2020, 57, 351–358. [Google Scholar] [CrossRef]
- Ding, D.; Zhu, Q. Recent Advances of PLGA Micro/Nanoparticles for the Delivery of Biomacromolecular Therapeutics. Mater. Sci. Eng. C Mater. Biol. Appl. 2018, 92, 1041–1060. [Google Scholar] [CrossRef]
- Goy, R.C.; de Britto, D.; Assis, O.B.G. A Review of the Antimicrobial Activity of Chitosan. Polímeros 2009, 19, 241–247. [Google Scholar] [CrossRef]
- Blumer, J. Meropenem: Evaluation of a New Generation Carbapenem. Int. J. Antimicrob. Agents 1997, 8, 73–92. [Google Scholar] [CrossRef]
- Pfaller, M.A.; Jones, R.N. A Review of the in Vitro Activity of Meropenem and Comparative Antimicrobial Agents Tested against 30,254 Aerobic and Anaerobic Pathogens Isolated World Wide. Diagn. Microbiol. Infect. Dis. 1997, 28, 157–163. [Google Scholar] [CrossRef]
- Claessens, J.; Roriz, M.; Merckx, R.; Baatsen, P.; Van Mellaert, L.; Van Eldere, J. Inefficacy of Vancomycin and Teicoplanin in Eradicating and Killing Staphylococcus Epidermidis Biofilms in Vitro. Int. J. Antimicrob. Agents 2015, 45, 368–375. [Google Scholar] [CrossRef]
- Sun, S.; Zhang, Y.; Zeng, D.; Zhang, S.; Zhang, F.; Yu, W. PLGA Film/Titanium Nanotubues as a Sustained Growth Factor Releasing System for Dental Implants. J. Mater. Sci. Mater. Med. 2018, 29, 141. [Google Scholar] [CrossRef]
- Ren, Y.; Zhao, X.; Liang, X.; Ma, P.X.; Guo, B. Injectable Hydrogel Based on Quaternized Chitosan, Gelatin and Dopamine as Localized Drug Delivery System to Treat Parkinson’s Disease. Int. J. Biol. Macromol. 2017, 105, 1079–1087. [Google Scholar] [CrossRef]
- Ni, M.; Zhuo, S.; So, P.T.C.; Yu, H. Fluorescent Probes for Nanoscopy: Four Categories and Multiple Possibilities. J. Biophoton 2017, 10, 11–23. [Google Scholar] [CrossRef]
- Brown, C.M. Fluorescence Microscopy—Avoiding the Pitfalls. J. Cell Sci. 2007, 120, 1703–1705. [Google Scholar] [CrossRef]

| Bacteria | Material | Mean ± SD | Median | Range | Mean Rank | K-W p-Value ** |
|---|---|---|---|---|---|---|
| SA | PLGA | 0.00 | 0.00 | 0.00 | 5.00 | 0.006 * |
| MP | 29.67 ± 0.58 | 30.00 | 1.00 | 17.00 | ||
| CH | 0.00 | 0.00 | 0.00 | 5.00 | ||
| MC | 21 ± 1.73 | 20.00 | 3.00 | 13.00 | ||
| MEM | 20 ± 1.0 | 20.00 | 2.00 | 12.00 | ||
| Uncoated | 0.00 | 0.00 | 0.00 | 5.00 | ||
| PA | PLGA | 0.00 | 0.00 | 0.00 | 3.50 | 0.005 * |
| MP | 18.33 ± 1.15 | 19.00 | 2.00 | 17.00 | ||
| CH | 8.33 ± 1.15 | 9.00 | 2.00 | 8.00 | ||
| MC | 13.33 ± 1.15 | 14.00 | 2.00 | 11.67 | ||
| MEM | 14.33 ± 0.58 | 14.00 | 1.00 | 13.33 | ||
| Uncoated | 0.00 | 0.00 | 0.00 | 3.50 |
| Bacteria | Materials | Mean ± SD | p-Value | 95% Confidence Interval | Multiple Comparison Test | ||||||
|---|---|---|---|---|---|---|---|---|---|---|---|
| Lower Bound | Upper Bound | PLGA | MP | CH | MC | MEM | Uncoated | ||||
| SA | PLGA | 2.60 ± 0.49 | 0.000 * | 1.38 | 3.83 | 1 | |||||
| MP | 3.36 ± 0.21 | 2.84 | 3.88 | 0.456 | 1 | ||||||
| CH | 2.47 ± 0.42 | 1.43 | 3.51 | 1.000 | 0.252 | 1 | |||||
| MC | 3.69 ± 0.38 | 2.74 | 4.64 | 0.264 | 0.892 | 0.144 | 1 | ||||
| MEM | 14.03 ± 0.65 | 12.41 | 15.64 | 0.000 * | 0.003 * | 0.000 * | 0.144 | 1 | |||
| Uncoated | 57.99 ± 0.74 | 56.16 | 59.82 | 0.000 * | 0.000 * | 0.000 * | 0.001 * | 0.000 | 1 | ||
| PA | PLGA | 1.58 ± 0.11 | 0.000 * | 1.30 | 1.85 | 1 | |||||
| MP | 1.90 ± 0.23 | 1.32 | 2.47 | 0.544 | 1 | ||||||
| CH | 2.71 ± 0.21 | 2.18 | 3.25 | 0.024 | 0.080 | 1 | |||||
| MC | 3.47 ± 0.26 | 2.82 | 4.12 | 0.013 | 0.012 | 0.133 | 1 | ||||
| MEM | 24.24 ± 0.23 | 23.67 | 24.82 | 0.000 * | 0.000 * | 0.000 * | 0.000 * | 1 | |||
| Uncoated | 94.09 ± 0.23 | 93.51 | 94.67 | 0.000 * | 0.000 * | 0.000 * | 0.000 * | 0.000 * | 1 | ||
| Materials | Bacteria | Mean ± SD | p-Value |
|---|---|---|---|
| PLGA | SA | 2.60 ± 0.49 | 0.062 |
| PA | 1.58 ± 0.11 | ||
| MP | SA | 3.36 ± 0.21 | 0.001 * |
| PA | 1.90 ± 0.23 | ||
| CH | SA | 2.47 ± 0.42 | 0.452 |
| PA | 2.71 ± 0.21 | ||
| MC | SA | 3.69 ± 0.38 | 0.462 |
| PA | 3.47 ± 0.26 | ||
| MEM | SA | 14.03 ± 0.65 | 0.000 * |
| PA | 24.24 ± 0.23 | ||
| Uncoated | SA | 57.99 ± 0.74 | 0.000 * |
| PA | 94.09 ± 0.23 |
| Material | SA% | PA% |
|---|---|---|
| PLGA | 94.10 | 93.73 |
| CH | 97.26 | 83.28 |
| MEM | 63.79 | 40.70 |
| MP | 42.63 | 38.79 |
| MC | 46.61 | 46.61 |
| Uncoated | 99.74 | 99.43 |
| Test | CFU n (104) | ZOI Mean in mm | MTT % Live Bacteria | Confocal Microscope % Live Bacteria | |||||
|---|---|---|---|---|---|---|---|---|---|
| Material | SA | PA | SA | PA | SA | PA | SA | PA | |
| PLGA | 28 | 83 | 0.00 | 0.00 | 2.60 | 1.58 | 94.10 | 93.73 | |
| MP | 0 | 22 | 29.67 | 18.33 | 3.36 | 1.90 | 97.26 | 83.28 | |
| CH | 30 | 39 | 0.00 | 8.33 | 2.47 | 2.71 | 63.79 | 40.70 | |
| MC | 0 | 27 | 21 | 13.33 | 3.69 | 3.47 | 42.63 | 38.79 | |
| MEM | 3 | 3 | 20 | 14.33 | 14.03 | 24.24 | 46.61 | 46.61 | |
| Uncoated | 164 | 327 | 0.00 | 0.00 | 57.99 | 94.09 | 99.74 | 99.43 | |
Publisher’s Note: MDPI stays neutral with regard to jurisdictional claims in published maps and institutional affiliations. |
© 2022 by the authors. Licensee MDPI, Basel, Switzerland. This article is an open access article distributed under the terms and conditions of the Creative Commons Attribution (CC BY) license (https://creativecommons.org/licenses/by/4.0/).
Share and Cite
Al-Qubaisey, M.; Khounganian, R.; Al-Badah, A. Microbiological Assessment of Titanium Plates Coated with PLGA, Chitosan, and/or Meropenem: An In Vitro Study. Antibiotics 2022, 11, 1565. https://doi.org/10.3390/antibiotics11111565
Al-Qubaisey M, Khounganian R, Al-Badah A. Microbiological Assessment of Titanium Plates Coated with PLGA, Chitosan, and/or Meropenem: An In Vitro Study. Antibiotics. 2022; 11(11):1565. https://doi.org/10.3390/antibiotics11111565
Chicago/Turabian StyleAl-Qubaisey, Mohammad, Rita Khounganian, and Abdulhakim Al-Badah. 2022. "Microbiological Assessment of Titanium Plates Coated with PLGA, Chitosan, and/or Meropenem: An In Vitro Study" Antibiotics 11, no. 11: 1565. https://doi.org/10.3390/antibiotics11111565
APA StyleAl-Qubaisey, M., Khounganian, R., & Al-Badah, A. (2022). Microbiological Assessment of Titanium Plates Coated with PLGA, Chitosan, and/or Meropenem: An In Vitro Study. Antibiotics, 11(11), 1565. https://doi.org/10.3390/antibiotics11111565
